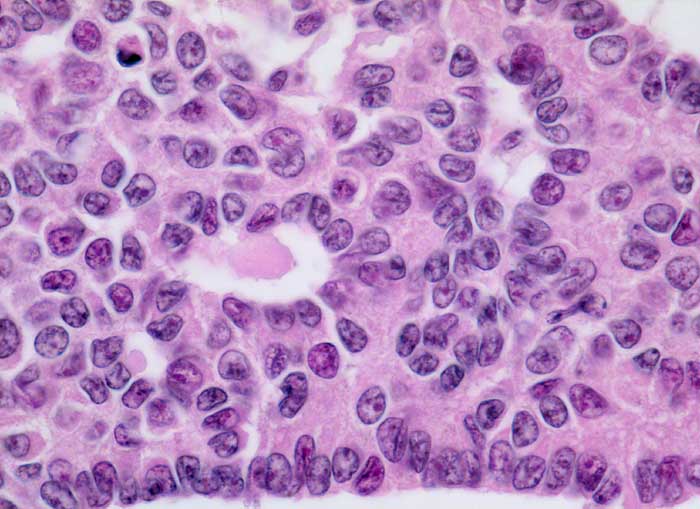

PathoPic – image database / PathoPic ID 5396 - Granulosazelltumor
de
Diagnose
Granulosazelltumor
Diagnose Gruppe
maligner Tumor
Topographie
Ovar
Topographie Gruppe
Genitalorgane, weiblich
Beschreibung
Zusatzbefund
Tumorzellen positiv für alpha Inhibin
Klinik
Ovarialtumor von 12cm Durchmesser
Bilder Typ
Histologie
Vergrösserung
630
Alter
85
Geschlecht
unbekannt
Datum
Ersteintrag: 20.11.2002
Update: 10.08.2010